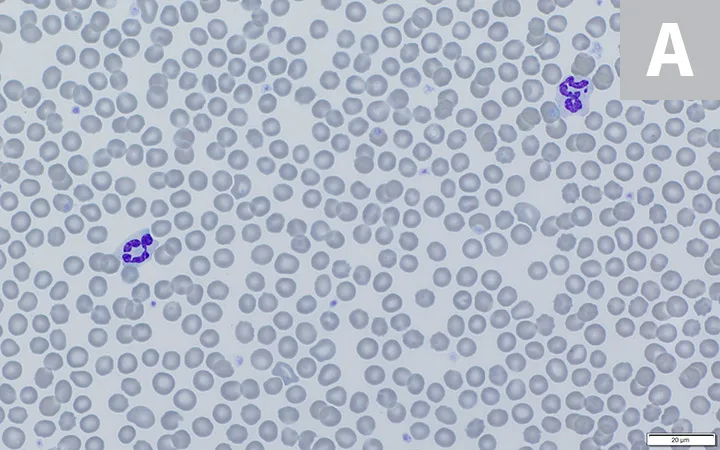
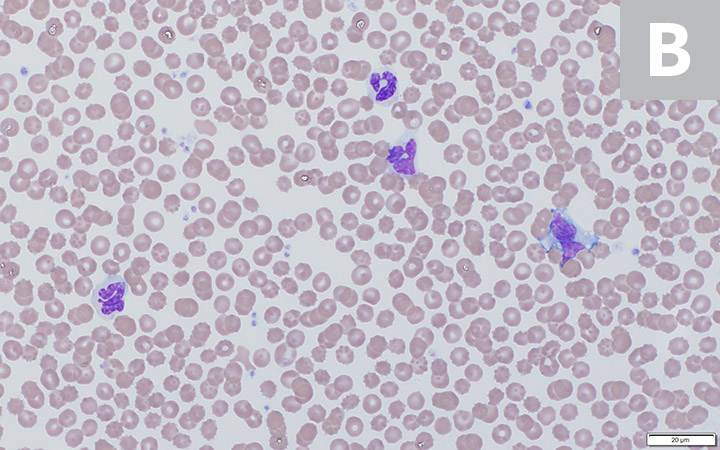
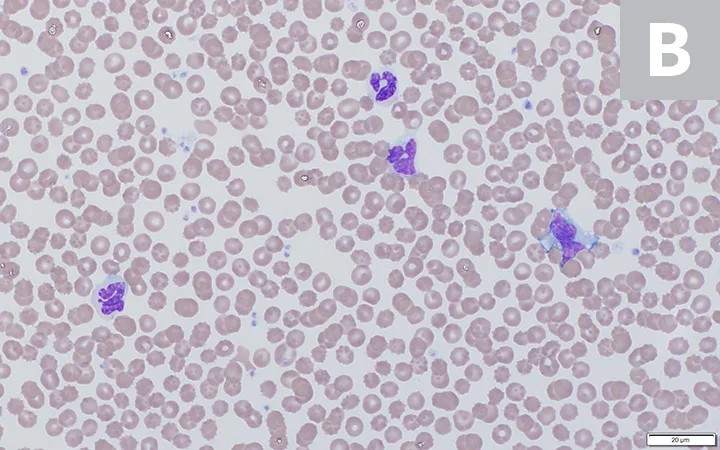

Errors in commercial and in-clinic veterinary laboratories can be classified as: preanalytic, analytic, or postanalytic.1 Preanalytic errors are most common in human and veterinary laboratories and are typically associated with oversights in sample collection and handling.2 Analytic errors are connected to the precision, accuracy, sensitivity, and specificity of instruments or methods, and postanalytic errors can be associated with transcriptional errors or misinterpretation of presented data.
Following are 5 of the most common causes of blood collection and sample-handling errors that result in preanalytic erroneous laboratory results, according to the authors.
1. Nonfasted Patient
Increased triglycerides that cause lipemia may be the result of an underlying pathologic mechanism. However, lipemia is most commonly seen as a postprandial change in nonfasted patients (Figures 1 and 2). Lipemia increases the turbidity of serum and/or plasma, resulting in disturbances to hematologic and biochemical assays that rely on light scattering (eg, total protein by refractometry, hemoglobin and related indexes, bilirubin).1

FIGURE 1
Lipemic blood from a nonfasted dog. This sample was refrigerated overnight, allowing the RBCs to settle and thereby accentuate the lipemic nature of the plasma (arrow).
Excess lipids can also cause a false decrease in measured electrolytes depending on the method of analysis used. Many analyzers employ indirect potentiometry to determine the electrical potential of ions in plasma or serum. Samples measured via indirect potentiometry are diluted by the analyzer prior to analysis. In cases of lipemia, addition of the diluent can result in a false decrease in measured electrolyte concentrations because the increased triglycerides cause a phenomenon called volume displacement, in which the lipids in plasma/serum water exclude electrolytes (eg, sodium, potassium, chlorine) in a lower aqueous volume.1 Many point-of-care blood–gas analyzers use direct potentiometry, which does not rely on a diluted measurement of electrolytes and thus does not result in falsely decreased electrolyte concentrations. However, the simplest way to avoid errors related to lipemia is to require pet owners to fast the patient 8 to 12 hours prior to examination and planned blood collection.
2. In vitro Hemolysis
Hemolysis (ie, lysis of erythrocytes that results in pink to red serum [Figure 3] or plasma) is classified as either pathologic (ie, in vivo) or artifactual (ie, in vitro). In vitro hemolysis may be associated with traumatic sample collection, improper sample handling, extreme temperatures, and/or delayed processing.3,4 In vitro hemolysis decreases erythrocyte concentration; however, in the absence of in vivo hemolysis, the hemoglobin concentration is accurate because measurement of hemoglobin for many analyzers requires lysis of all erythrocytes followed by light transmission assessment.1 Artifactual decrease in the erythrocyte concentration can also cause alterations to index results that include the erythrocyte concentration in the calculation (eg, calculated hematocrit, mean corpuscular hemoglobin concentration).

Hemolytic serum
Absorbance spectrophotometry is used to measure the concentration of many biochemical analytes (eg, bilirubin, urea nitrogen, creatine kinase, phosphorus, cholesterol) and measures the amount of light that passes through a solution that contains the analyte (ie, product of an enzymatic reaction) of interest.5 Measured wavelengths are then compared with the known absorption spectrum for the substance of interest.5 Free hemoglobin absorbs light, thus the presence of free hemoglobin can interfere with the test, leading to inaccurate test results.1 In addition, marked in vitro hemolysis can result in the release of ions and molecules that are found in higher concentrations in intracellular fluids; spurious increases of ALT, AST, phosphorous, and potassium (depending on the species) can potentially be encountered.1
In vitro hemolysis can be prevented through use of atraumatic venipuncture with proper patient restraint and handling, proper sample collection (eg, large-bore needle), and proper sample handling (eg, gentle mixing with anticoagulant and prompt analysis). Refrigeration of the sample is necessary when sample analysis is delayed, but samples should not be placed directly on ice to decrease hemolysis.3
3. Clotted Sample
Prolonged blood collection, traumatic venipuncture, and/or inadequate mixing of whole blood with an anticoagulant can result in a clotted sample. Specimens with large clots are at risk for obstructing tubing, injectors, and filters in expensive equipment and are not appropriate for sample analysis. To avoid costly errors, it is recommended to look for large clots (Figure 4) prior to analysis with commercial laboratory or in-clinic bench top analyzers.

Blood clot in an EDTA tube. Visual observation for large clots is recommended prior to analysis, but wood stick applicators (as shown) are also excellent tools for this purpose.
Microscopic clots or platelet clumps (Figure 5) associated with zealous platelet aggregation, especially in cats, can result in false thrombocytopenia (ie, pseudothrombocytopenia).3,6 In addition, impedance analyzers differentiate erythrocytes and platelets by size, which can result in misclassification of small platelet clumps (or large platelets) as erythrocytes.3,4,6 Several techniques (eg, vortex mixing, addition of prostaglandins) to prevent or disrupt platelet aggregation have been investigated to avoid this effect7; however, widespread use of any method—beyond careful collection and handling—is not apparent, and all reported thrombocytopenias should be verified via blood smear review.7

Large platelet clump (arrow and inset) in a blood sample from a dog
4. Insufficient Sample Volume (ie, Short Sample)
Collection of minute sample volumes or use of an inappropriately large tube can result in unfavorable results due to dilution by excess anticoagulant or insufficient sample volume to run requested assays. Blood collection tubes should be filled to the specified tube volume, which is usually indicated by a subtle fill line (Figure 6).

EDTA tube that was submitted to a reference laboratory and contains an insufficient amount of blood for the tube size selected. A subtle fill line (arrow) is visible.
EDTA anticoagulant is hypertonic as compared with blood; the difference in tonicity, however, does not result in clinically significant changes to CBC results if the EDTA tube is appropriately filled. When an EDTA tube is not adequately filled, the excess volume of EDTA anticoagulant relative to whole blood instigates osmotic movement of intracellular water to the relatively hypertonic plasma/anticoagulant solution in an attempt to equalize tonicity, resulting in shrinkage of erythrocytes (crenation) and a falsely decreased packed cell volume from the spun hematocrit.4 When blood from an EDTA tube is run through a hematology analyzer to perform a CBC, the analyzer suspends RBCs in a diluent that is isotonic to normal plasma. In samples with excess EDTA, the diluent is hypotonic (not isotonic) as compared with the shrunken RBC; the fluid rushes back into the cells and volume is regained. Therefore, the calculated hematocrit from a short sample is the accurate value.4
Appropriate volume is especially important for coagulation testing. Most coagulation profiles require citrated plasma at an anticoagulant:whole-blood ratio of 1:9 to allow for reversal of anticoagulative effects by addition of calcium during the analytic process.8 In underfilled samples, the ratio of citrate to whole blood is increased and results in decreased coagulation, leading to falsely prolonged clotting times.8
In cases in which low sample volume is anticipated, the minimal sample volume and recommended sample-handling techniques for the desired analyte should be requested from a reference laboratory.
5. Delayed Processing
Ideally, hematologic and biochemical samples should be processed and analyzed as soon as possible after collection. However, this may not always be possible, and erroneous results can occur because of delayed processing. Hematologic data that may be affected include an increased mean corpuscular volume (MCV) due to erythrocyte swelling, resulting in further alterations to MCV-associated indexes (eg, increased calculated hematocrit, decreased mean cellular hemoglobin concentration).9,10 These changes are typically initially observed 12-hours postcollection and continue to increase in magnitude with time.9,10
Morphologic changes compatible with pseudotoxic change (Figure 7) can also be observed in blood smears as early as 4-hours postcollection when stored at room temperature, 8-hours postcollection when stored with ice packs, or 24-hours postcollection at 39°F (4°C).11 Examples of morphologic changes in neutrophils associated with prolonged storage include increased cytoplasmic basophilia, increased cytoplasmic vacuolation, and the presence of Döhle bodies. The current hypothesis attributes the formation of these changes to increased cellular permeability with prolonged storage, resulting in staining of structures that may not have previously been visible.11 These changes may be misinterpreted as true cytoplasmic toxic change and may have clinical implications; thus, it is important to consider this change when interpreting the leukogram.

Comparison of blood from a healthy dog submitted to laboratory for presurgical CBC stained with the same stain but prepared 24-hours apart. Monolayer of blood film prepared within an hour of collection (A). Segmented neutrophil with normal morphology characterized by dark condensed chromatin and definitive indentations of the nucleus can be seen. Erythrocytes exhibit normal morphology with central pallor and smooth edges. Blood film prepared after being refrigerated for 24 hours to demonstrate aging artifact (B). The neutrophil nucleus is less condensed and lighter pink with smoother (almost hyalinized) chromatin; this can be confused with toxic change. Erythrocytes are crenated; some no longer exhibit the expected central pallor typical of RBCs in healthy dogs.
In addition to morphologic changes seen in leukocytes, storage-associated morphologic changes are also noted in erythrocytes. Of particular importance is the dislodgement of epicellular hemoparasites (eg, feline Mycoplasma spp) from the surface of erythrocytes with prolonged storage; this may result in an overlooked parasitemia.12 Increased crenation of erythrocytes can also be observed with delayed processing.4 To minimize the implications of artificially induced changes associated with prolonged storage, preparation of blood films is strongly encouraged immediately postcollection for examination or submission to a laboratory.
For biochemical testing, blood should be clotted (15-30 minutes) and centrifuged to separate cellular elements from serum.3 Once separated from cellular elements, serum should be analyzed promptly or refrigerated for up to 24 to 48 hours.3 Delayed separation and removal of serum inevitably leads to metabolism of chemical constituents, notably a reduction in glucose.3 Serum enzymes are especially at risk for erroneous results with delayed processing (>24 hours) due to enzyme activity and kinetics.3 If a delay is expected, it can be helpful to schedule adjustments or discuss with a reference laboratory whether the desired analyte is stable in frozen serum.
Conclusion
Recognizing these collection and sampling errors can help prevent erroneous results and help interpret results when these situations cannot be avoided. When submitting a sample to a reference laboratory, clinicians should communicate known collection and handling errors to help ensure accurate interpretation by the clinical pathologist. Although not included in this article, sample collection via an indwelling catheter, if not performed using recommendations previously described, can result in multiple clinically significant errors such as falsely decreased HCT and other values from dilution of fluids, falsely increased values (eg, glucose, potassium) secondary to contamination by administered substances, and hemolysis secondary to excessive suction. Resources for proper placement and use of sampling catheters are available (see Suggested Reading).